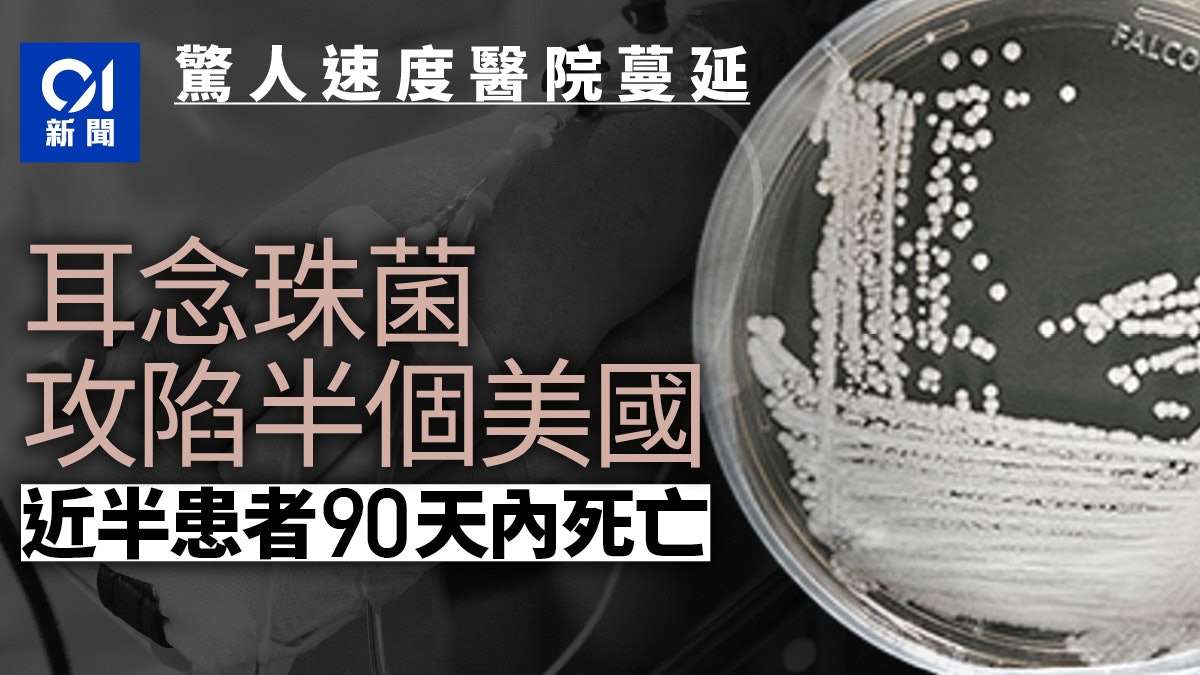

內華達州「超級真菌」感染激增 33%:數據顯示 CDC 低估災情
新聞來源:賭城天天報發佈作者:本報記者晨楓發佈時間:2026-01-12
記者晨楓報導,被美國衛生官員列為「超級真菌」的耳念珠菌(Candida auris)在內華達州正迅速蔓延。根據州政府最新報告,過去一年該類感染病例增長了 33%。令人擔憂的是,聯邦疾病控制與預防中心(CDC)先前公布的數據未能完全反映現實,其記錄的 1,605 例感染案比州政府實際掌握的數據少了 137 例,且未包含 2025 年的最新情況。 截至 2025 年底,內華達州已錄得 2,324 例臨床感
記者晨楓報導,被美國衛生官員列為「超級真菌」的耳念珠菌(Candida auris)在內華達州正迅速蔓延。根據州政府最新報告,過去一年該類感染病例增長了 33%。令人擔憂的是,聯邦疾病控制與預防中心(CDC)先前公布的數據未能完全反映現實,其記錄的 1,605 例感染案比州政府實際掌握的數據少了 137 例,且未包含 2025 年的最新情況。
截至 2025 年底,內華達州已錄得 2,324 例臨床感染案例,另有 4,937 例定殖(colonization)案例。臨床感染意味著真菌已進入病患血液或傷口,具備高度致死風險。專家指出,耳念珠菌能長期存活於醫院家具與醫療設備表面,對多種抗真菌藥物具有耐藥性。
拉斯維加斯的 Sunrise 醫院與醫療中心是目前感染數字最高的設施。該院醫療長 Sherrie Somers 博士強調,病患安全是首要任務,醫院已實施超越 CDC 建議的嚴格篩查與清潔技術。
醫學專家表示,耳念珠菌的死亡率高達 20% 至 40%,且多發生於本身已有其他基礎疾病的重症病患身上。提高公眾意識與加強醫療設施的感染控制,是當前防止真菌大規模擴散的關鍵。